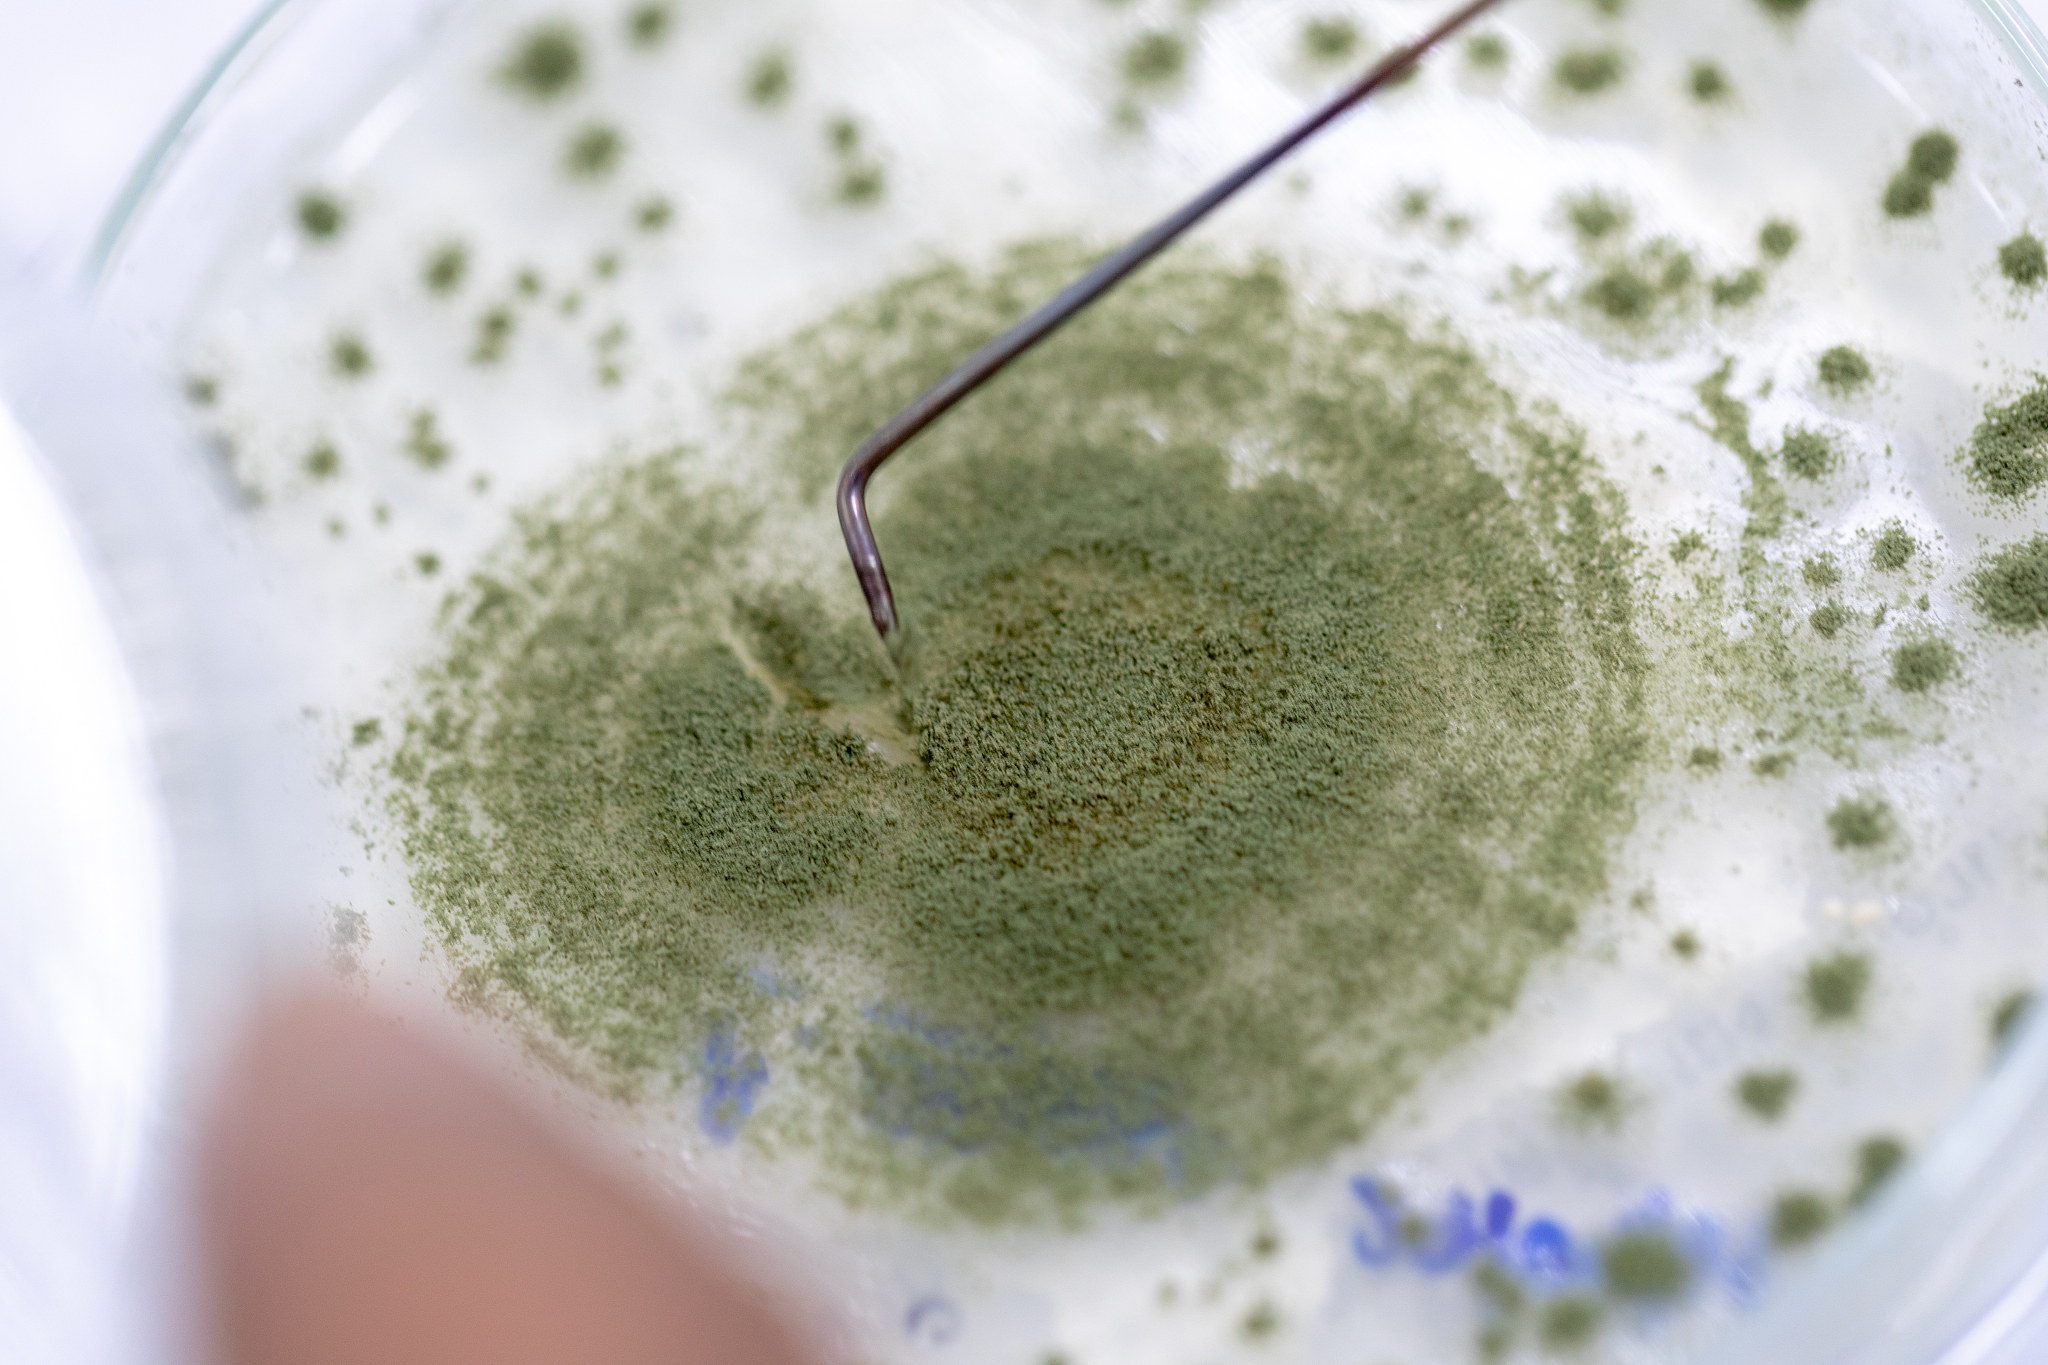
大豆水分和温度条件下霉菌易生长：ERH超过70%

大豆水分和温度条件下霉菌易生长:ERH超过70%
从货物的水分含量和温度来看,大豆的平衡相对湿度(ERH)很容易超过70%,从而满足霉菌的生长环境。

原文地址: https://www.cveoy.top/t/topic/fSwW 著作权归作者所有。请勿转载和采集!
安全问答是一个知识全球问答,包含丰富的问答知识
从货物的水分含量和温度来看,大豆的平衡相对湿度(ERH)很容易超过70%,从而满足霉菌的生长环境。
原文地址: https://www.cveoy.top/t/topic/fSwW 著作权归作者所有。请勿转载和采集!